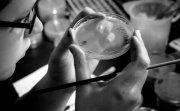
Person with petri dish

A THING Tank Primer
From DIY microscopes made from paper and household items, to low-cost sensors measuring air quality in communities around the world, the things of science -- that is, the physical tools that generate data or contribute to scientific processes -- are changing the way that science happens.
The following selection of work explores the questions of: Will low-cost and/or open tools scale, replacing expensive, proprietary designs? Will the use of these tools fundamentally change how we generate data and knowledge, and apply it to global problems? Will the result be more, and better, science? And if so, what is standing in the way of widespread adoption and use?
Funding for the THING tank is provided by the Alfred P. Sloan Foundation.
Introduction to low-cost and open source tools toolkit
Learn More